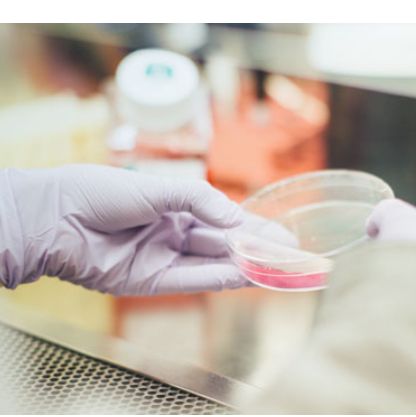
「DIFF CRO」NDV载体构建服务

搜索到 200 条记录

动物建模平台
万类生物现有占地面积近1万平米的现代化生物医学实验室,下设产品研发中心、测序服务中心、SPF实验动物中心、CRO服务中心。凭借完备的仪器设备和优秀的技术人员,目前已建立起完善的免疫学、分子生物学、病理学、高通量测序以及转基因技术平台。
地区:沈阳市沈北新区服务名称:动物建模平台
询价

梅特勒托利多 瑞宁RAININ 移液器校准免费体验
瑞宁RAININ 移液器校准校准体验卡 ——免费体验值得信赖的移液器校准! 可体验类型:产品分类:单道移液器校准、8道移液器校准、12道移液器校准 试用规则:每人可得5张校准体验卡,共限量100张,申请前20位可得。 每张卡可享受2支单道或1支多道移液器的CNAS校准服务和预防性
询价

心肌药筛
,药物心脏毒性模型等。可利用MEA系统对心肌细胞进行实时无标记检测,跟踪检测疾病模型细胞加药前后的相关功能数据的变化,进行药效的评估及有效药物的筛选。 化合物心肌毒性检测 在药物的开发过程中,药物的心脏毒性是不可忽视的安全评价部分。传统的药物心脏毒性检测一般需要建立动物模型,或者采
地区:中国服务名称:人源细胞药物安全评价

HE 染色
伊红染色法 ( hematoxylin-eosin staining ) ,简称HE染色法 ,石蜡切片技术里常用的染色法之一 。 HE染色法是组织学、胚胎学、病理学教学与科研中最基本、使用最广泛的技术方法。 实验原理 易于被碱性或酸性染料着色的性质称为嗜碱性( basophili
地区:全国服务名称:HE 染色

中长链脂肪酸靶向代谢组学
分泌、免疫细胞等多个生物过程的调控。目前有一些发现,使用中长链脂肪酸的油脂有降低血脂、降低胆固醇、降低体脂的作用。随着脂肪营养研究的深入,脂肪酸的营养作用、生物功能以及与疾病健康的关系日益受到人们广泛的关注。 靶向产品列表 技术优势 1、高通量,可同时对多种中长链脂肪酸进行定性定量
地区:全国服务名称:中长链脂肪酸靶向代谢组学服务

PTAH染色实验
【实验原理】 PTAH染色,纤维胶质,肌胶质,神经胶纤维,纤维素,横纹肌等均染成蓝色,胶原,网状纤维和骨基质着黄色或砖红色。在工作中常用于观察横纹以证实肿瘤细胞是否有横纹肌分化特征。 【实验流程】 1.石蜡切片脱蜡至水。 2. Lugol 氏碘液媒染 2~3 小时 3. 蒸馏水洗

血常规、血生化、血凝检测
南京博恩生物技术有限公司 官网:www.biornscience.com 邮箱:biornservice@163.com 咨询电话:17714345757
地区:全国服务名称:血常规、血生化、血凝检测
询价

生殖技术培训及定制化业务
生殖技术培训 (1)培训内容:目前公司对外开发的技术培训,包括胚胎操作类技术、分子实验类技术等。其中胚胎操作类技术包括,生物净化、精子冷冻及复苏、胚胎冷冻及复苏、胚胎移植等相关技术;分子实验类技术包括,DNA的提取、PCR、Southern检测等。 (2)培训时间:公司每年2期对
地区:全国服务名称:小鼠模型定制

TRAP
TRAP(tagged RNA affinity purification)是一种检测与RNA结合的蛋白质(RBPs)的检测方法。 TRAP方法首先通过设计GST-MS2融合表达载体和ncRNA-MS2茎环结构串联重复载体,共转细胞获得GST-MS2融合蛋白和ncRNA-MS2融
地区:全国服务名称:TRAP

目标小分子定量
目标小分子定量属于靶向代谢组学分析,利用多反应监测MRM技术,同时对样品中多种目标小分子的含量进行快速、精确地测定,小分子广义上包括肽类、氨基酸类、脂类物质、核苷酸类物质、花生四烯酸类、有机酸类、类固醇类、胆汁酸,次生代谢产物以及药物毒品等等。可应用于药代动力学,毒药检测,临床研
询价

CUT&Tag:全方位、全流程、一站式科研服务
服务价格: 根据您不同的要求进行试验设计,具体价格欢迎您致电咨询:010-51668388。 项目周期: 最快1-2周。 服务流程: 数据分析流程: 案例展示: 1.H3K4me1抗体的CUT&Tag数据显示,与IgG对照组相比,H3K4me1 CUT&Tag检测到了H3K4me
地区:全国服务名称:CUT&Tag:全方位、全流程、一站式科研服务
询价
「DIFF CRO」NDV载体构建服务
「DIFF CRO」NDV载体构建服务 「DIFF CRO」NDV载体构建优势: 服务案例:「DIFF CRO」NDV溶瘤病毒候选株对成瘤小鼠肿瘤的抑制作用: 图1.以NDV为载体的改造溶瘤病毒候选株(NDV-OV1,NDV-OV2,NDV-OV3)给药后,成瘤小鼠肿瘤体积变化。A
¥30000

真核/原核表达载体-用途广泛/载体多样/表达载体价格低-辉骏生物
产品简介 原核表达载体用于在原核细胞中表达外源基因,从克隆载体发展而来,除具备克隆载体的一般特点外,还需有调控外源基因有效转录和翻译的序列,如启动子、核糖体结合位点、转录终止序列等。目前应用最广泛的是大肠杆菌表达载体。 哺乳动物细胞表达载体是可以在哺乳动物细胞中表达外源基因的载体,
文献支持地区:全国服务名称:哺乳动物细胞表达载体—辉骏生物

氧化脂质
· 产品介绍 氧化脂质是PUFA发生自动氧化,或在环氧合酶(cyclooxygenase, COX)、脂氧合酶(lipoxygenase, LOX)、细胞色素P450(cytochrome P450, CYP)的作用下生成的一系列氧化代谢产物。PUFA通常以磷脂的形式储存在膜中,经
文献支持地区:全国服务名称:氧化脂质

基因定点突变( Site-directed mutagenesis)
基因定点突变(Site-directed mutagenesis):向目的DNA片段中引入所需变化,包括碱基的添加、删除、点突变等。定点突变能迅速、高效的提高DNA所表达的目的蛋白的性状及表征,是基因研究工作中一种非常有用的手段。 服务内容:根据客户的突变要求,突变模板质粒中单个
服务名称:基因定点突变( Site-directed mutagenesis)提供商:简石生物技术(浙江)有限公司

组织特异性条件性点突变小鼠模型
组织特异性条件性点突变小鼠模型 一、组织特异性条件性点突变小鼠模型: 指点突变能被引入特定细胞或组织中目的基因位置的小鼠模型。突变蛋白的表达水平及表达谱与野生蛋白的表达一致,并在小鼠的整个发育时期都有表达。 二、优势与不足: 优势:能避免常规点突变导致的致死表型(胚胎干细胞致死、
地区: 全国服务名称:组织特异性条件性点突变小鼠模型

肿瘤免疫小鼠模型
。不管是癌症免疫治疗还是肿瘤发生发展、肿瘤微环境的机理研究,这些复杂的、系统性的研究当然都离不开动物模型的应用。在此就一一细数 IO 研究中用到的小鼠模型,全是干货哦~ 图片来源:站酷海洛 1. 自发、诱导的小鼠肿瘤及其移植瘤模型 正常的小鼠在大约一年半的生命周期里也有可能罹患癌症
地区:北京服务名称:肿瘤免疫小鼠模型

ABI 一代测序仪维修维护
我公司有专业的工程师团队和充足的仪器配件,可提供ABI一代测序仪维修维护服务,包括仪器型号有:ABI 310、ABI 3100A、ABI 3100、ABI 3130、ABI 3130XL、ABI 3730、ABI 3730XL. 欢迎来电垂询。
服务名称:ABI 一代测序仪维修维护提供商:ABI
询价















